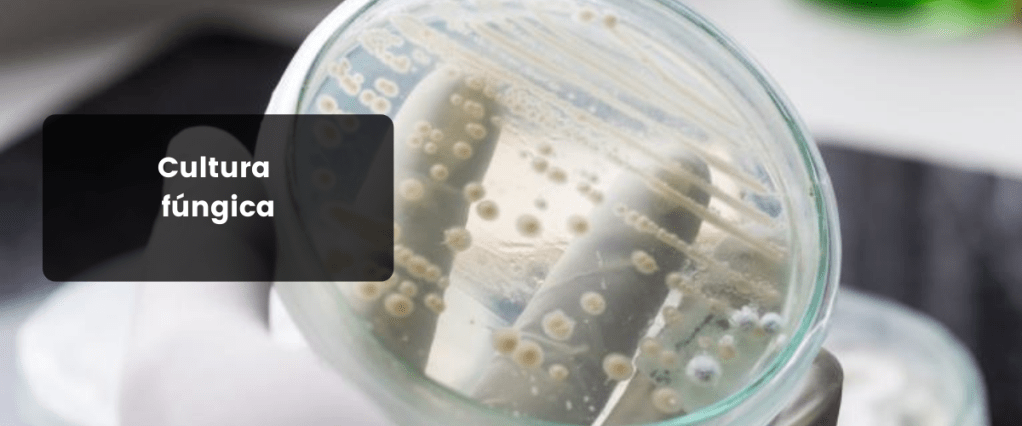

As soluções para os problemas de pele começam com o estabelecimento de diagnósticos precisos. Aqui na Dermato 4 Pets, os exames dermatológicos são realizados e interpretados, em sua maioria, durante a consulta.
O melhor tratamento é aquele que soma eficácia, redução de efeitos colaterais e custo acessível para a sua família. Sua participação é fundamental nessa escolha. Juntos, formamos uma equipe com um único objetivo: melhorar a qualidade de vida do seu pet!